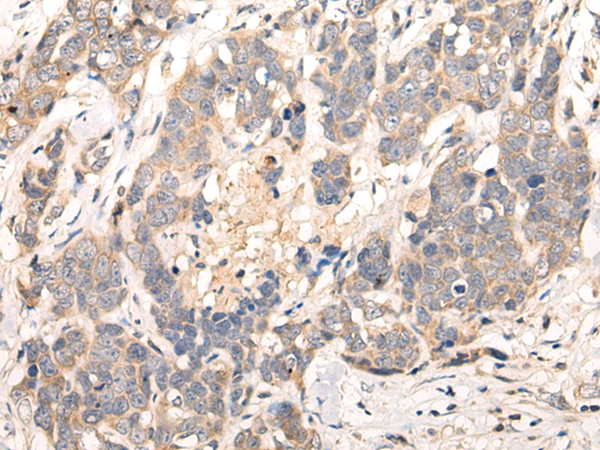
一抗

技術(shù)規(guī)格
Background:
The protein encoded by this gene belongs to the family of G-protein coupled receptors, that are preferentially activated by adenosine and uridine nucleotides. This gene aligns with an internal intron of the retinoblastoma susceptibility gene in the reverse orientation. Alternative splicing results in multiple transcript variants.
Applications:
ELISA, IHC
Name of antibody:
LPAR6
Immunogen:
Synthetic peptide of human LPAR6
Full name:
lysophosphatidic acid receptor 6
Synonyms:
LAH3; P2Y5; ARWH1; HYPT8; P2RY5
SwissProt:
P43657
ELISA Recommended dilution:
5000-10000
IHC positive control:
Human thyroid cancer and human ovarian cancer
IHC Recommend dilution:
10-50


 購物車
購物車 幫助
幫助
 021-54845833/15800441009
021-54845833/15800441009